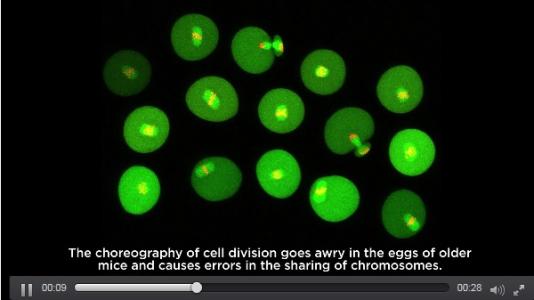

FERTILITÉ : Pourquoi elle décline naturellement avec l'âge
Cette découverte d’une équipe de l’Université de Montréal pourrait mener un jour à de nouveaux traitements de fertilité pour aider les femmes un peu plus âgées à concevoir et mener une grossesse à terme. Elle montre en effet que l’infertilité féminine liée à l'âge peut s’expliquer par un défaut dans la chorégraphie du partage des chromosomes dans les ovules lors de la division cellulaire. Les chercheurs canadiens testent déjà des techniques de micro-intervention, directement dans les ovules, qui permettraient d'inverser ce problème et de rajeunir les ovules.
Les chercheurs du Centre de recherche du Centre hospitalier de l'Université de Montréal (CRCHUM), grâce à des techniques de microscopie avancées, observent, pour la première fois un défaut particulier dans les ovules (ovocytes) de souris. Ce défaut se retrouverait également dans les ovules de femmes plus âgées. Lors de la division cellulaire, la chorégraphie dérape et entraîne des erreurs dans le partage des chromosomes : « Nous avons découvert que les microtubules qui orchestrent la séparation des chromosomes lors de la division cellulaire sont anormaux dans les ovules plus âgés. Au lieu de former une structure qui se déploie de façon contrôlée et parfaitement symétrique, appelée le fuseau, les microtubules vont dans toutes les directions », résume l'auteur principal, Greg FitzHarris, professeur à l'Université de Montréal.
Ce défaut dans les ovules qui leur confère un nombre anormal de chromosomes : vers l'âge de 35 ans chez la femme, la fertilité diminue de façon importante et l'une des causes principales serait ce défaut de nombre anormal de chromosomes dans les ovules. Ces ovules aneuploïdes, de plus en plus fréquents au fur et à mesure du vieillissement contribuent à expliquer cette baisse de fertilité liée à l'âge.
A l'hypothèse de la « perte de cohésion chromosomique », s'ajoutent des défauts dans les microtubules qui causent des fuseaux défectueux et contribuent également à un type particulier d'aneuploïdie : les fuseaux constitués d'un assemblage de microtubules rassemblent et trient les chromosomes au moment de la division cellulaire et les expédient aux deux extrémités des cellules filles dans un processus appelé ségrégation chromosomique. Les chercheurs constatent ici, chez la souris, qu'environ 50% des ovules de femelles plus âgées présentent un fuseau ayant une architecture et une dynamique de microtubules chaotiques. Or ces défauts du fuseau sont aussi un problème chez l'humain. En somme, c'est la machinerie cellulaire qui fonctionne moins bien en vieillissant, peu importe l'âge des chromosomes.
Ces données vont permettre de travailler au développement de techniques de micro-intervention, directement dans les ovules, qui vont tenter d'inverser ce problème pour rajeunir les ovules. Cependant, « il faudra encore plusieurs années de recherche avant d'en arriver là », concluent les chercheurs.
3 avril 2017 DOI: 10.1016/j.cub.2017.02.025 Instrinsically defective microtubule dynamics contribute to age-related chromosome segregation errors in mouse oocyte meiosis-I (Vidéo@laboratoire de Greg FitzHarris, CRCHUM)
Plus d'études sur la Fertilité
Autres actualités sur le même thème
GROSSESSE : La prévalence de l’hypertension artérielle explose
Actualité publiée il y a 1 année 9 moisCOVID-19 et ALLAITEMENT : Pourquoi même traitée, la mère devrait allaiter
Actualité publiée il y a 5 années 11 moisPRÉÉCLAMPSIE : Le test d'urine Congo Red Dot pour un diagnostic précoce
Actualité publiée il y a 6 années 11 moisIST: Un spray nasal contre la chlamydia ?
Actualité publiée il y a 9 années 8 mois




